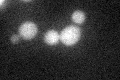
YNR033W
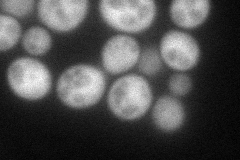
YNR033W
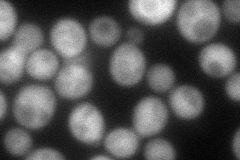
YNR033W
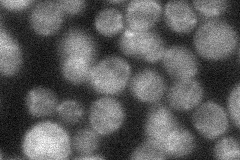
YNR033W
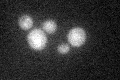
YNR033W

View description
Para-aminobenzoate (PABA) synthase, has similarity to Escherichia coli PABA synthase components PabA and PabB
Localization:
Intensity:
Fold change:
Significance:
-
C’ GFP library in SD
cytosol29.72 -
N' NOP1pr-GFP in SD
cytosol66.4445 -
N' TEF2pr-mCherry in SD
cytosol83.0868 -
N' NATIVEpr-GFP in SD
ambiguous26.9464 -
N' TEF2pr-VC and Cyto-VN in SD

#N/A0 -
C’ GFP library in SD+DTT

cytosol30.221.01No -
C’ GFP library in SD+H2O2

cytosol32.731.1No -
C’ GFP library in Starvation Media
cytosol37.091.24No -
C’ GFP library on the background of Pup2-DaMP

cytosol -
C’ GFP library on the background of CCT mutant

cytosol35.51921.19498No
